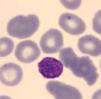

Las enfermedades relacionadas con mutaciones del gen MYH9 son un grupo de patologías genéticas raras. Su herencia sigue un patrón autosómico dominante en donde el gen MYH9, codifica la cadena pesada de la miosina IIA no muscular que se expresa en diferentes tejidos pero especialmente en los podocitos y en las células mesangiales. Este trastorno se caracteriza por la presencia de macrotrombocitopenia, inclusiones leucocitarias y un riesgo variable de desarrollar insuficiencia renal, hipoacusia y cataratas en edad juvenil o adulta. Describimos el caso de una mujer de 27 años, de raza caucásica, diagnosticada inicialmente de púrpura trombocitopénica idiopática. Tras una detallada historia familiar y el desarrollo de síntomas clínicos posteriores con afectación renal e hipoacusia, se le realizó un estudio genético que nos permitió el diagnóstico de nefropatía asociada a la mutación en el gen MYH9. Este caso destaca el retraso del diagnóstico y la utilidad del estudio genético en pacientes con enfermedades muy poco frecuentes. Se procede a la revisión de la enfermedad en este artículo.
MYH9 related diseases are caused by mutations in the MYH9 gene and constitute a rare group of genetic entities. Its inheritance follows an autosomal dominant pattern. The MYH9 gene, encodes the nonmuscle myosin heavy chain IIA, expressed in different tissues and especially in podocytes and mesangial cells. The disorder is characterized by the presence of macrothrombocytopenia, leukocyte inclusions and a variable risk of developing renal failure, hearing loss and early-onset cataracts. We describe the case of a 27-year-old Caucasian woman, diagnosed initially with idiopathic thrombocytopenic purpura. After a detailed family history and the appearance of renal involvement and hearing loss, genetic testing allowed to make the diagnosis of nephropathy associated with MYH9 mutation. This case is an example of the delayed diagnosis of uncommon diseases and highlights the usefulness genetic testing. A review of the disease is provided.
Las enfermedades relacionadas con mutaciones del gen MYH9 son un grupo de patologías genéticas ultrarraras que se caracterizan por la presencia de macrotrombocitopenia, inclusiones leucocitarias y un riesgo variable de desarrollar insuficiencia renal, hipoacusia y cataratas en edad juvenil o adulta1. El Registro italiano para enfermedades asociadas a mutaciones en el gen MYH9 incluye 108 individuos afectados, lo que indica que la prevalencia del trastorno en Italia es de al menos 3: 1.000.000. Debido a que las formas leves se descubren incidentalmente y las formas graves a menudo se diagnostican erróneamente, quizás la prevalencia real sea más alta2.
Se transmite a partir de una herencia autosómica dominante, es decir que el alelo mutado es dominante sobre el normal y es suficiente una sola copia mutada para que se exprese la enfermedad, pudiendo afectar con igual probabilidad a varones y mujeres. Por lo tanto, cada individuo afecto tiene una probabilidad del 50% de transmitir la enfermedad a su descendencia.
Evolución históricaEl grupo de enfermedades causadas por mutación en el gen MYH9 se agrupaban en cuatro síndromes caracterizados por presentar macrotrombocitopenia asociada a otras enfermedades. Históricamente estos síndromes se correspondían con3–5:
- -
Anomalía de May-Hegglin.
- -
Síndrome de Fechtner.
- -
Síndrome de Epstein.
- -
Síndrome de Sebastian.
Tanto el síndrome de Epstein como el de Fechtner, en los que la afectación renal está presente, habían sido considerados clásicamente como variantes del síndrome de Alport6. Por otra parte, el síndrome de Sebastian y la anomalía de May-Hegglin se presentan sin afectación renal, manifestándose únicamente por la presencia de inclusiones leucocitarias y afectación ocular o auditiva.
Estos cuatro trastornos, caracterizados por trombocitopenia con plaquetas gigantes, se clasificaron en función de los aspectos morfológicos de los cuerpos tipo Döhle y las diferentes combinaciones de las otras manifestaciones de mutación en MYH9: pérdida de la audición, nefropatía glomerular y cataratas. Sin embargo, debido a que el fenotipo de una persona con una variante patogénica en MYH9 a menudo evoluciona con el tiempo, el cuadro clínico de un individuo puede cambiar con el tiempo según la aparición de un nuevo hallazgo. Además, los cuatro síndromes no definen todas las manifestaciones posibles derivadas de las variantes patogénicas heterocigotas en MYH9. Finalmente, los miembros de la misma familia pueden tener diferentes fenotipos y recibir diferentes diagnósticos dentro del espectro de enfermedades asociadas a mutaciones en el gen MYH9. Por estas razones, las patologías asociadas a MYH9 han sido propuestas como una nueva entidad nosológica que incluye a todos los individuos con variantes patogénicas heterocigotas en MYH9 independientemente del aspecto de los neutrófilos y el fenotipo clínico7. Los 4 síndromes históricamente conocidos, son entidades genéticamente distintas al síndrome de Alport que era el principal diagnóstico diferencial8.
Por otra parte, los avances en la secuenciación masiva de genes, han permitido en estos últimos años el análisis de diferentes variantes a nivel intrónico e incluso polimorfismos o haplotipos de riesgo en MYH9, relacionados con la glomeruloesclerosis focal y segmentaria idiopática, la nefropatía hipertensiva y la enfermedad renal crónica terminal tanto en diabéticos como no diabéticos9–11. En España, el estudio EPIRCE demostró que alrededor del 10% de la población presenta algún grado de enfermedad renal crónica12–14 y para profundizar en el estudio de las posibles causas genéticas de cronicidad, Tavira et al. mediante el estudio español RENASTUR demostró cierta asociación entre el polimorfismo rs3752462 de MYH9 y el riesgo de desarrollar enfermedad renal crónica15. Apoyando estos resultados, en un estudio de casos y controles, se ha descrito la asociación del polimorfismo rs3752462 de MYH9 en pacientes con hipertensión arterial y enfermedad renal crónica en China16. En modelos animales con variantes en MYH9 que alteran la estructura del citoesqueleto del podocito, también se ha observado que el estímulo con agentes secundarios como fármacos nefrotóxicos (doxorrubicina y adriamicina), infección por HIV e hipertensión arterial favorecen el deterioro de función renal y la aparición de albuminuria17–19.
PatogeniaMYH9 es un gen constituido por 40 exones, localizado en el cromosoma 22q y codifica para la cadena nonmuscle myosin heavy chain IIA (NMMHC IIA). Esta proteína forma parte de la superfamilia de las proteínas motoras, presentes en todas las células eucariotas, y tiene importantes funciones en la estabilización del citoesqueleto. Se trata de una enzima hexamérica con dos cadenas ligeras y dos cadenas pesadas que presentan un dominio N-terminal y un dominio C-terminal20. La NMMHC IIA mutada no se expresa en las plaquetas y se agrega en los leucocitos, lo cual da lugar a la presencia de inclusiones leucocitarias que son características en esta enfermedad. La formación de macroplaquetas podría explicarse por una producción precoz y ectópica de plaquetas en el intersticio de la médula ósea. En estudios realizados con megacariocitos de ratones, se considera que esto podría deberse a una alteración en la vía Rho-associated kinase-myosin light chain (Rho-ROCK-MLC) de la trombopoyesis regulada por la NMMHC IIA21,22.
Al mismo tiempo, como las cadenas pesadas de miosina se expresan en los podocitos y en las células mesangiales del glomérulo, se justifica la presencia de proteinuria y la evolución a enfermedad renal crónica en los pacientes afectos1,17.
Características clínicas de las patologías asociadas a mutaciones en el gen MYH9- a)
Manifestaciones relacionadas con la trombocitopenia:
- -
Hematomas frecuentes.
- -
Sangrado excesivo tras medidas de hemostasia (cirugías mayores o menores, tratamiento con antiagregantes plaquetarios)23.
- b)
Hipoacusia neurosensorial. Puede aparecer entre la 1.ª y 6.ª década de la vida24,25.
- c)
Afectación ocular: cataratas de aparición precoz (ocurren en edad temprana o media y son detectadas con lámpara de hendidura)26,27.
Afectación renal: se ha observado en el 30% de los pacientes con mutaciones en este gen. Se caracteriza por proteinuria de inicio temprano, con o sin microhematuria, y rápida progresión a enfermedad renal crónica. La nefropatía asociada a mutación del gen MYH9, habitualmente progresa a enfermedad renal crónica terminal alrededor de los 30 años, aunque también se han detectado casos de edad más avanzada1,14,28.
Antecedentes familiares con patrón de herencia autosómica dominante. La ausencia de un historial familiar de enfermedad relacionada con mutaciones en MYH9 no excluye el diagnóstico. La expresión clínica en los familiares afectos puede ser muy variable.
Alteraciones analíticas y al microscopio- -
Trombocitopenia.
- -
El frotis de sangre periférica demuestra al microscopio: plaquetas grandes (diámetro medio de plaquetas> 3,7μm y/o> 40% de plaquetas con diámetro> 3,9μm) o cuerpos tipo Döhle en el citoplasma de los neutrófilos. Cabe destacar que los cuerpos tipo Döhle están presentes en el 42-84% de los pacientes con mutaciones en MYH929.
- -
La inmunofluorescencia de un frotis de sangre periférica demuestra agregados de proteína MYH9 típicos en el citoplasma de los neutrófilos4,30,31. Es importante destacar, que en los neutrófilos de individuos no afectados, la proteína MYH9 está distribuida uniformemente.
- -
Elevación de los niveles de creatinina, indicando la progresión a insuficiencia renal y riesgo de enfermedad renal terminal.
- -
Elevación crónica de transaminasas32.
- -
Análisis de orina: proteinuria y microhematuria. La proteinuria es el signo más temprano de afectación renal33–35.
Si la sospecha clínica es muy alta, se puede realizar el análisis del gen MYH9 o la utilización de un panel de genes, que además nos permite hacer el diagnóstico diferencial con otras patologías clínicamente similares36.
Correlaciones fenotipo-genotipoLa identificación de la variante patogénica MYH9 específica de la familia puede ayudar a evaluar el riesgo de desarrollar las manifestaciones clínicas no congénitas de la enfermedad.
Los individuos afectados con variantes patogénicas que implican el dominio principal de la proteína MYH9 tienen trombocitopenia más grave en comparación con aquellos con variantes patógenicas que afectan el dominio de los extremos. El riesgo de desarrollar daño renal, pérdida de la audición y catarata también depende de la variante patogénica MYH9 específica.
- •
La sustitución p.Asp1424His se asocia a un riesgo intermedio o alto de desarrollar manifestaciones no congénitas de la enfermedad. La mayoría de las personas afectadas con la variante p.Asp1424His desarrollan enfermedad renal antes de los 60 años. La mayoría de los pacientes afectos por esta variante desarrollarán hipoacusia dentro de los 60 años y el riesgo de cataratas es mayor que en aquellos con otros genotipos.
- •
Las sustituciones p.Asp1424Asn y p.Glu1841Lys, así como las variantes patogénicas nonsense o frameshift, se asocian con bajo riesgo de desarrollar manifestaciones no congénitas de la enfermedad. En individuos con estas variantes patógenas, la trombocitopenia generalmente sigue siendo la única manifestación de la enfermedad a lo largo de la vida37.
La ausencia de trombocitopenia en otros miembros de la familia no excluye la presencia de mutación en MYH9 porque la frecuencia de variantes de novo es alta (35% de los probandos)38.
El diagnóstico diferencial debe tener en cuenta las formas adquiridas y congénitas de trombocitopenia, así como las nefropatías relacionadas con el colágeno IV:
- a)
Trombocitopenia adquirida. Diferenciar MYH9 de formas adquiridas de trombocitopenia puede ser difícil y varios individuos con enfermedad por MYH9 han sido diagnosticados erróneamente con púrpura trombocitopénica idiopática (PTI) (autoinmune). Esto condujo a la administración de tratamientos (fármacos inmunosupresores y esplenectomía) que son ineficaces en individuos con esta enfermedad. Cuando no hay un antecedente familiar de trombocitopenia, la evaluación de la extensión de sangre periférica es una herramienta simple y efectiva para distinguir a los individuos con enfermedad por MYH9 de aquellos con PTI, ya que las plaquetas son significativamente más grandes en personas con enfermedad MYH9 que en aquellos con PTI. En particular, un diámetro medio de plaquetas > 3,7μm distingue MYH9 de PTI con un 86% de sensibilidad y un 87% de especificidad. De lo contrario, una proporción de plaquetas con un diámetro > 3,9μm (aproximadamente la mitad de un glóbulo rojo) superior al 40%, diferencia a MYH9 de la PTI con un 85% de sensibilidad y un 87% de especificidad39.
- b)
Trombocitopenias congénitas40:
- -
Síndrome de Bernard-Soulier (BSS) (OMIM 231200).
- -
Síndrome de plaquetas grises (OMIM 139090).
- -
Citopenia ligada a X relacionada con mutaciones en el gen GATA1.
- -
Trombocitopenias asociadas a mutciones en los genes MPL y MECOM.
- c)
Nefropatías relacionadas con el colágeno IV, incluidas las formas ligadas a X y autosómicas (dominantes y recesivas) del síndrome de Alport. El espectro de la enfermedad de Alport es muy amplio, algunos pacientes con herencia autosómica dominante pueden presentar solamente hematuria microscópica persistente, que rara vez progresa a insuficiencia renal. En cambio los pacientes con síndrome de Alport ligado a X o herencia recesiva, presentan hematuria, proteinuria, insuficiencia renal progresiva y enfermedad renal terminal. También presentan anomalías extrarrenales, incluida la pérdida auditiva neurosensorial progresiva (generalmente presente al final de la niñez o principios de la adolescencia), lenticono anterior, maculopatía, vesículas endoteliales corneales y erosión corneal recurrente. Los defectos plaquetarios no se han descrito en la enfermedad de Alport. Por lo tanto, cuando una nefropatía se asocia con macrotrombocitopenia, se debe tener en cuenta patologías relacionadas con mutaciones en el gen MYH98.
El diagnóstico diferencial con el síndrome de Alport resulta difícil frecuentemente, pues ambas entidades pueden presentarse como una enfermedad glomerular hereditaria con proteinuria, insuficiencia renal progresiva e hipoacusia bilateral neurosensorial. La trombocitopenia nos dirigirá el diagnóstico hacia una enfermedad por MYH9.
Tratamiento y prevención- a)
Alteraciones hematológicas.
- •
Medidas locales (compresión, cauterización, aplicación de gasas con ácido tranexámico) son el tratamiento de primera línea para el sangrado mucocutáneo y a menudo son suficientes para controlar el sangrado leve o moderado.
- •
Transfusiones de plaquetas.
- •
Eltrombopag. Interactúa con la trompoyetina humana induciendo la proliferación y diferenciación de los megacariocitos desde las células progenitoras de la médula ósea. Se ha descrito que este fármaco oral aumentaba los recuentos de plaquetas y suprimía la tendencia hemorrágica en la mayoría de los casos de pacientes con mutaciones en MYH941,42.
- •
Antifibrinolíticos. Algunos autores recomiendan la administración sistémica de agentes antifibrinolíticos, como ácido tranexámico o epsilon-aminocaproico, para tratar el sangrado mucocutáneo leve o moderado20.
- •
La desmopresina como profilaxis acorta el tiempo de sangrado en ciertas cirugías de pacientes con enfermedad por MYH9. Como no todos los individuos responden al tratamiento, se recomienda una dosis de prueba para identificar a aquellos que se beneficiarán de este tratamiento en la prevención de hemorragias al realizar procedimientos invasivos o en futuros episodios de hemorragia37,43.
- b)
Hipoacusia. La utilización de implantes cocleares en pacientes con hipoacusia grave mejora las habilidades de comunicación verbal gracias a la restauración de la audición44–46.
- c)
Afectación ocular. La cirugía de cataratas mejora la opacidad de la lente.
- d)
Afectación renal.
- •
La proteinuria suele mejorar mediante el tratamiento con inhibidores del sistema renina angiotensina aldosterona47.
- •
La diálisis o el trasplante renal son el tratamiento para aquellos pacientes con insuficiencia renal terminal.
- e)
Afectación hepática. La elevación de las enzimas hepáticas no requiere ningún tratamiento específico.
- f)
Mujeres en edad reproductiva.
- -
Los anticonceptivos orales son efectivos para prevenir o controlar la menorragia; sin embargo, aumentan el riesgo de trombosis, que también se ha descrito en individuos con mutaciones en el gen MYH9. Por lo tanto, debe considerarse el equilibrio entre los riesgos y beneficios asociados con el uso de anticonceptivos orales3.
- -
Los partos deben manejarse como en mujeres con otras formas de trombocitopenia. Las mujeres embarazadas cuya trombocitopenia y antecedentes hemorrágicos antes del embarazo son más graves, tendrán una mayor incidencia de sangrado relacionado con el parto. En los partos vaginales en mujeres con trombocitopenia grave, habrá que considerar un mayor riesgo de hemorragia intracraneal neonatal39.
- g)
Consejo genético. La herencia es de transmisión autosómica dominante, por lo tanto cada individuo tiene el 50% de probabilidades de transmitir la enfermedad a su descendencia. El diagnóstico prenatal y el diagnóstico preimplantacional son posibles, siempre y cuando se conozca previamente la mutación en el gen MYH9 en el progenitor.
Una mujer de 27 años había sido diagnosticada de trombocitopenia durante la infancia en el contexto de diátesis hemorrágica. Al diagnóstico presentaba plaquetas entre 3.000 y 10.000/l con hemorragias frecuentes. Inicialmente se orientó como una púrpura trombocitopénica idiopática. Se inició tratamiento con glucocorticoides y gammaglobulina endovenosa sin mejoría en el recuento plaquetar.
A los 5 años del diagnóstico se realizó esplenectomía sin éxito terapéutico para mejorar la trombocitopenia. Ante la trombocitopenia persistente, se realizó un estudio de sangre periférica observando macrodismorfia plaquetar (plaquetas gigantes con trastornos en la granulación), serie roja con hematíes dismórficos con presencia de cuerpos de Howell-Jolly, probablemente atribuibles a la asplenia, y ausencia de alteraciones en la serie blanca.
Como presentaba hemorragias frecuentes y anemización, precisó tratamiento continuo con hierro oral y transfusiones plaquetarias en cada acto quirúrgico.
A los 4 años fue diagnosticada de hipoacusia neurosensorial bilateral. La pérdida auditiva progresó lentamente, utilizando audífonos bilaterales, hasta que a los 26 años fue derivada a un centro especializado y se colocó un implante coclear en el oído izquierdo. Los resultados logoaudiométricos postimplante coclear resultaron excelentes (figs. 1-3). En el estudio preoperatorio se realizó una valoración del riesgo de sangrado mediante tromboelastograma que resultó ser normal a pesar de la trombocitopenia. La extensión de sangre evidenció plaquetas de gran tamaño y anomalías en la granulación. No se observaron inclusiones citoplasmáticas en los neutrófilos (fig. 4). El estudio oftalmológico fue normal.
Al mismo tiempo, se objetivó un descenso de proteínas totales a 55g/l (VN 64-83), albúmina sérica a 27g/l (VN 34-48), proteinuria 2,7g/24horas, creatinina 0,9mg/dl y CKD-EPI 86ml/min/1,73m2. Se remitió al Servicio de Nefrología por el cuadro de síndrome nefrótico con leves edemas en extremidades inferiores e hipercolesterolemia asociada. Debido al riesgo de sangrado por la trombocitopenia grave no se realizó biopsia renal y se inició tratamiento con lisinopril 5mg/día.
Se revisó la historia familiar, destacando que la madre también presentaba trombocitopenia idiopática, aunque menos acentuada que en la paciente, con recuentos plaquetarios entre 40-50.000/l (VN:140.000-350.000). También presentaba hipoacusia progresiva bilateral desde la infancia con utilización de audífonos bilaterales sin signos de nefropatía. Se confirmó la presencia de hipoacusia familiar, destacando afectación del bisabuelo, abuelo, tías abuelas y tía directa de rama materna. Ante la sospecha de enfermedad familiar, se realizó estudio genético mediante panel de 140 genes asociados a enfermedades renales.
Se identificó la variante c.287C>T (p.Ser96Leu) en el exón 2 del gen MYH9. Se trata de una variante «missense» que da lugar al cambio del aminoácido serina a leucina en el lugar 96 de la proteína miosina 9. El estudio genético secundario de la madre de 54 años reveló la misma variante genética (fig. 5).
El análisis genético resulta de especial importancia en esta enfermedad, porque como se comentó anteriormente, la existencia de una correlación genotipo-fenotipo puede ser relevante para el pronóstico. Autores como Pecci et al. proponían que las mutaciones en el dominio N-terminal, se habían relacionado con una mayor incidencia de nefropatía, hipoacusia y trombocitopenia más grave respecto a las mutaciones del dominio C-terminal2,48. En nuestro caso, la paciente presentaba una mutación en el exón 2 del gen MYH9 (c.287C>T), determinando la sustitución en la proteína del aminoácido serina por leucina (p.Ser96Leu) en el dominio N-terminal. Sin embargo, aunque la localización de la mutación podría explicar la presentación clínica de la enfermedad, destaca la elevada variabilidad fenotípica que presentan individuos con la misma mutación, como es el caso de nuestra paciente que presenta una afectación clínica mucho más grave que la de su madre. Estudios de los mismos autores publicados posteriormente, sugieren que no todos los pacientes con mutaciones en el dominio N-terminal comparten el mismo pronóstico37. Sin embargo, en el resto de los pacientes afectos, se considera la influencia de factores ambientales o de variantes en otros genes adicionales que interaccionan con MYH9 para determinar la progresión de la enfermedad como parece ser nuestro caso, debido a la elevada variabilidad intrafamiliar.
A pesar de realizar correctamente el tratamiento con ramipril, la paciente presentó deterioro progresivo de la función renal, con aumento de proteinuria a 3,6g/24 h y descenso del filtrado glomerular a 48ml/min/1,73 m2 en el año siguiente al diagnóstico. En el momento actual la paciente se encuentra en seguimiento multidisciplinar con el objetivo de detectar la aparición de posibles complicaciones relacionadas con su enfermedad.
Este caso revela la importancia de realizar una exhaustiva anamnesis familiar, especialmente cuando existe alta sospecha de enfermedades familiares de baja prevalencia. Sería recomendable obtener una historia familiar detallada con especial énfasis en las manifestaciones clínicas renales, auditivas y oftalmológicas cuando evaluamos a un niño con trombocitopenia. Ante una trombocitopenia no filiada, con historia familiar compatible, sería aconsejable la realización de un análisis de orina para descartar proteinuria y en caso de objetivarse, iniciar tratamiento temprano con inhibidores del sistema renina-angiotensina-aldosterona, con el objetivo de enlentecer la progresión de la enfermedad renal47.
ConclusionesEl diagnóstico de pacientes con nefropatía asociada a mutaciones en MYH9 no es fácil, como es el caso de nuestra paciente, siendo una enfermedad genética ultrarrara e infradiagnosticada. La utilización del diagnóstico genético mediante paneles de genes es de especial relevancia ya que permite llegar a un diagnóstico personalizado, fidedigno y vitalicio, aún desconociendo la enfermedad previamente. Además, permite el diagnóstico secundario de otros miembros de la familia y ofrece al paciente la posibilidad de consejo genético ante el deseo gestacional.
Es necesario nuevas líneas de investigación en cuanto al rol del gen MYH9 en las enfermedades renales así como la búsqueda de nuevas estrategias terapéuticas que nos permitan mejorar el pronóstico de los individuos afectos.
Conceptos clave- 1.
La nefropatía por mutaciones en MYH9 presenta un patrón de herencia autosómico dominante.
- 2.
Es un trastorno que se caracteriza por la presencia de macrotrombocitopenia, hipoacusia, cataratas y nefropatía proteinúrica con un riesgo variable de desarrollar insuficiencia renal.
- 3.
Se agrupan como con el nombre de enfermedades asociadas a MYH9 los grupos de patologías conocidas como: anomalía de May-Hegglin, síndrome de Fechtner, síndrome de Epstein y síndrome de Sebastian.
- 4.
Existen algunos polimorfismos en MYH9 que están asociados a mayor riesgo de desarrollar enfermedad renal crónica.
- 5.
El diagnóstico diferencial debe realizarse con otras causas de trombocitopenia y/o las nefropatías del colágeno IV.
- 6.
Cuando hay afectación renal con proteinuria, el tratamiento con inhibidores del sistema renina angiotesina podría enlentecer la evolución a enfermedad renal terminal.
- 7.
Aunque la localización de la mutación podría explicar la presentación clínica de la enfermedad, destaca la elevada variabilidad genotipo-fenotipo que presentan individuos con la misma mutación.
Los autores declaran no tener ningún conflicto de intereses.
A Ricard Pellejero, responsable de la Biblioteca de la Fundació Pyuigvert, por su asistencia en la búsqueda del material bibliográfico.